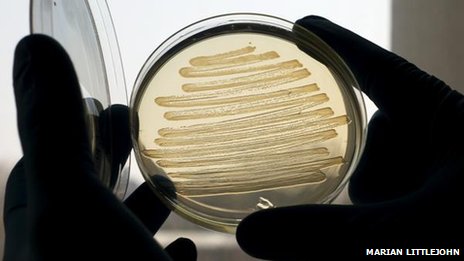
Кишечная палочка может производить дизельное топливо

Это может звучать невероятно, но учёные из Университета Эксетера нашли способ производить дизельное топливо, используя бактерию Escherichia coli(в простонародье — кишечная палочка). Полученное топливо почти ничем не отличается от обычного дизельного, получаемого из нефти. И что немаловажно, в отличие от биодизеля, такое топливо не требует смешивания с нефтепродуктами перед использованием. А значит, его применения не потребует каких либо модификаций существующих двигателей или изменений в топливной инфраструктуре.
Вот что говорит по этому поводу профессор с романтичной фамилией Джон Лав, ответственный за исследование:
Читать полностью »

